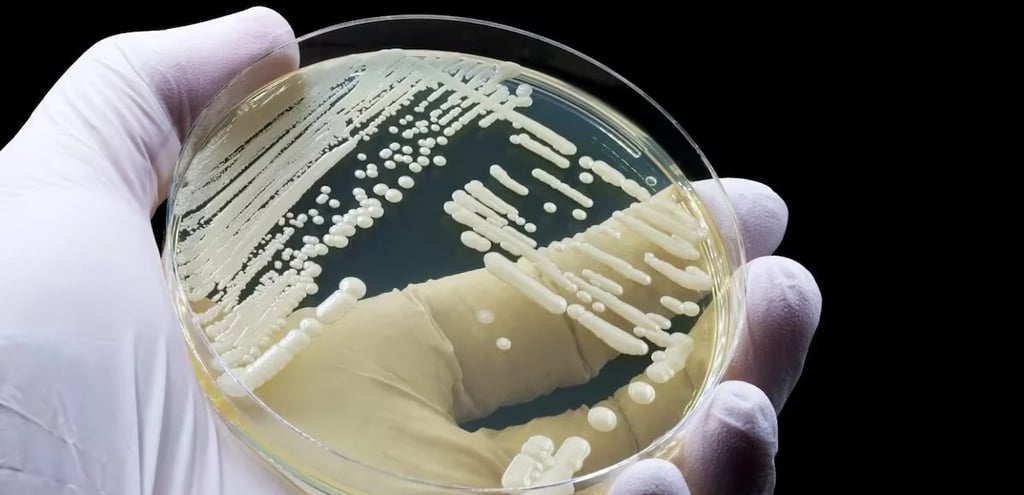
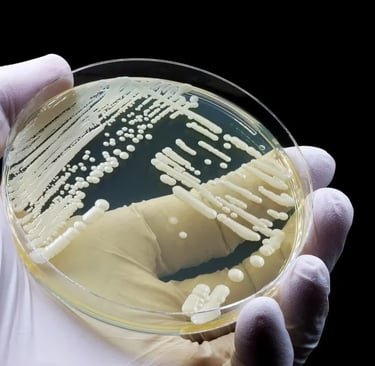

Super fungo Candida auris desafia hospitais no Brasil
Super fungo Candida auris desafia hospitais no Brasil: O Candida auris, um super fungo resistente a medicamentos, tem causado preocupação no Brasil, especialmente com novos casos em Belo Horizonte. Com alta mortalidade e difícil identificação, ele se espalha rapidamente em ambientes hospitalares, afetando principalmente pacientes debilitados. Especialistas correm para contê-lo, enquanto protocolos de segurança são reforçados para evitar sua propagação.
SAÚDE

Super fungo Candida auris desafia hospitais no Brasil.
No hospital, entre agulhas e exames, um novo personagem desafia a rotina médica: o Candida auris. Nome pomposo, mas a fama é a pior possível. Esse "superfungo", resistente a antifúngicos, é como aquele hóspede indesejado que não só fica, mas ainda traz confusão. Ele ataca preferencialmente os mais frágeis, hospitalizados há tempos. No Brasil, especialmente em Pernambuco, já houve surtos, e agora Minas Gerais também entrou no radar. Com capacidade de colonizar pele e ambiente, o alerta é geral, pois os números preocupam, e o tratamento é um verdadeiro quebra-cabeça.
O Hospital João XXIII, em Belo Horizonte, vive um momento tenso, mas não daqueles que se resolvem com um remédio e um sorriso. Com quatro casos confirmados de Candida auris e mais 24 suspeitos aguardando análise, a situação é delicada. O problema? Esse fungo não gosta de seguir as regras. Resistente aos tratamentos habituais, ele se espalha com uma facilidade irritante, colonizando tanto os pacientes quanto o ambiente ao redor. Resultado: isolamento preventivo dos casos, protocolos reforçados e uma torcida silenciosa por boas notícias nos exames.
O Candida auris, descoberto em 2009 no Japão, é aquele tipo de vilão que se esconde à vista de todos. Além de difícil de identificar – pode se passar por outras leveduras mais inofensivas – ele também resiste aos principais medicamentos antifúngicos. No Brasil, o primeiro caso apareceu em Salvador, em 2020, talvez como consequência do caos hospitalar durante a pandemia. Agora, com surtos em Belo Horizonte, o Ministério da Saúde reforça que, além de sua alta mortalidade, esse fungo adora se instalar em quem já está fragilizado.
E enquanto o Candida auris desafia médicos e protocolos, a batalha silenciosa dentro dos hospitais continua. Com taxas de mortalidade alarmantes, ele é mais que um invasor: é um lembrete de como, mesmo com toda a tecnologia, a saúde ainda pode ser frágil. A esperança está nas mãos de especialistas, que correm para identificar e conter esse inimigo microscópico. Para o público, resta a atenção redobrada: o superfungo pode não ser tão popular quanto vírus e bactérias, mas o estrago que causa é igualmente sério.
Fonte: noticias.uol.com.br


